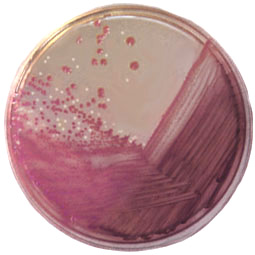

Large, dark pink colonies: ![]()
and small, pale colonies: ![]()
This is a MacConkey agar plate which accounts for the colour difference.
|
Note that there are two types of colony on the plate:
Large, dark pink colonies:
and small, pale colonies: This is a MacConkey agar plate which accounts for the colour difference. |
The objective of this experiment is to examine the two types of bacteria which give these different colony forms.